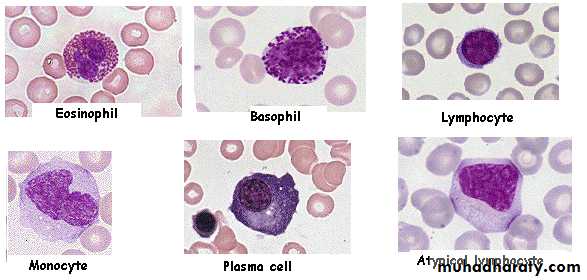
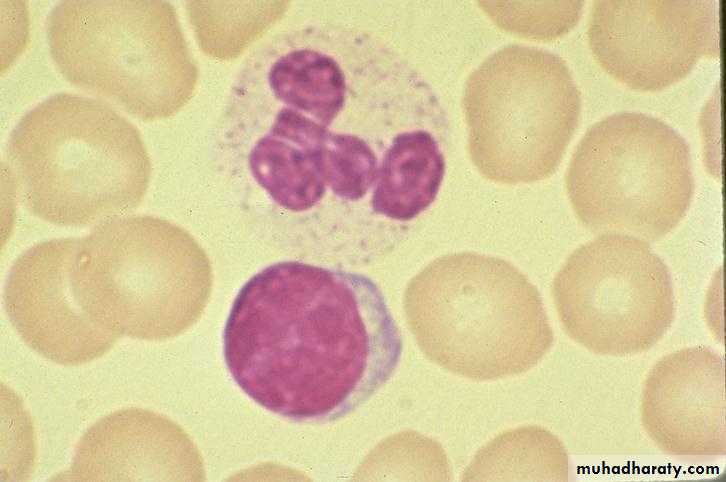

Peripheral blood smear
• Normal blood leucocytes morphology
NeutrophilLymphocyte
Skin infection Respiratory infection
Neutropenia;Fever and Infections due to reduced immunity, especially;
(Ecchymosis)
Thrombocytopenia;
Bleeding manifestations into the skin;( Petechiae)
• Organ and Tissue Infiltration by the leukemic cells:Splenomegaly..Hepatomegaly..Bone pain..Arthralgia..
Facial Palsy
Lymphadenopathy
Ant. chamber infiltration
Ocular infiltration
Tongue infiltration
Gum infiltration
Skin infiltration
Nodular lesionRaised erythematous lesion
ALL (Lymphoblasts)
The WBC's seen here are lymphocytes, but they are blasts--very immature cells with larger nuclei that contain nucleoli. Such lymphocytes are indicative of acute lymphocytic leukemia (ALL
AML (Myeloblasts)
Here are very large, immature myeloblasts with many nucleoli. A distincitve feature of these blasts is a linear red "Auer rod" composed of crystallized granules. These findings are typical for acute myelogenous leukemia (AML)
AML (Myeloblast with Auer rod)
Here are very large, immature myeloblasts with many nucleoli. A distincitve feature of these blasts is a linear red "Auer rod" composed of crystallized granules. These findings are typical for acute myelogenous leukemia (AML)